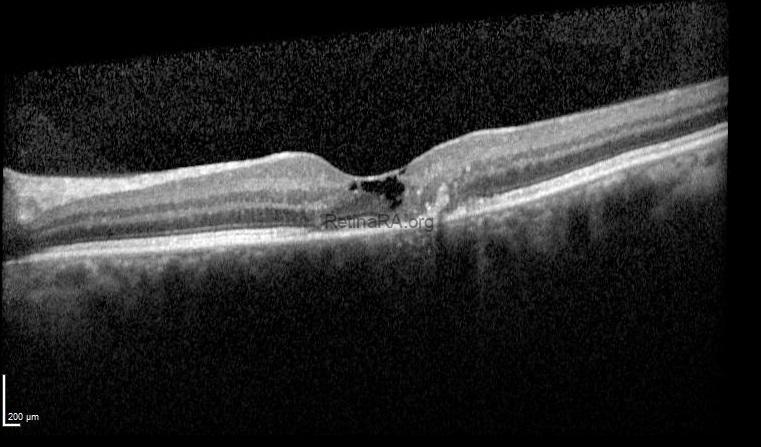
3

A 62-year-old woman presented to the outpatient clinic for near-vision correction. Best-corrected visual acuity was 20/32 in both eyes. Anterior segment examination was unremarkable, and intraocular pressures were within normal limits.
Fundus examination revealed subtle bilateral parafoveal loss of retinal transparency associated with small pigment clumps and right-angled venules in both eyes.


Optical coherence tomography demonstrated focal disruption of the ellipsoid zone and external limiting membrane, intraretinal hyporeflective cavities, hyperreflective foci with posterior shadowing, and an inner limiting membrane (ILM) drape sign.
These findings were consistent with macular telangiectasia type 2.
Macular telangiectasia type 2 (MacTel 2) is a bilateral, slowly progressive neurodegenerative macular disease that often remains underdiagnosed in routine practice. Patients may present with relatively preserved visual acuity despite complaints of reading difficulty, paracentral scotomas, or metamorphopsia. Funduscopic findings are typically subtle and include parafoveal loss of retinal transparency, right-angled venules, and pigment clumping in later stages. Optical coherence tomography plays a key role in diagnosis, demonstrating inner retinal cavitations, disruption of the ellipsoid zone and external limiting membrane, and the characteristic ILM drape sign. Recognition of these early structural changes is essential, as MacTel 2 is frequently mistaken for more common macular pathologies. Careful multimodal imaging allows timely diagnosis, appropriate counseling, and follow-up for potential neovascular complications.
Credit: Kemal Tekin, M.D., from Ulucanlar Eye Training and Research Hospital
Instagram accounts: @retina.academy and @dr.kemaltekin


